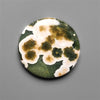

What Our Customers Say About Us
25k + Happy Customers
The quality of stones and balance of execution are Superior and Exactly what an Artisan wants. Communication is great. And shipping cost is a good value. Buyers will not be disappointed.

THEDEVINEMISST
I am always impressed with the quality of the stones I receive. The prices are very reasonable. Each shipment is somehow more beautiful than the last. Stones are packaged with care and arrive quickly. There are always many interesting stones during sales which makes them exciting. I hope to purchase many more stones in the future.

NANSHANNON
Really pleased when I received my order this week. Great quality gemstones, nicely packaged, great service and timely tracked delivery. looking forward to receiving my second order from you. Thank you.

BRANDON
⭐️⭐️⭐️⭐️⭐️ I love the gems I have bought from @cabochonsforsale they never fail to disappoint. They are always really well packaged. And exceptional quality. Not to mention that wow factor when I unwrap them for the first time. Thanks!

MYSILVERROAD
Was absolutely blown away by my order. Each piece was beautiful and a great price. Shipping was quick and my order was well packed. Customer service was amazing and so straight forward. I'm very happy with my order and will order again in the future. ❤️????????

DM.COPPERCREATIONS
I've always been super happy with my orders from you. The stones are always the quality pictured which is not always the case with other sellers. You are very professional and great at communicating.